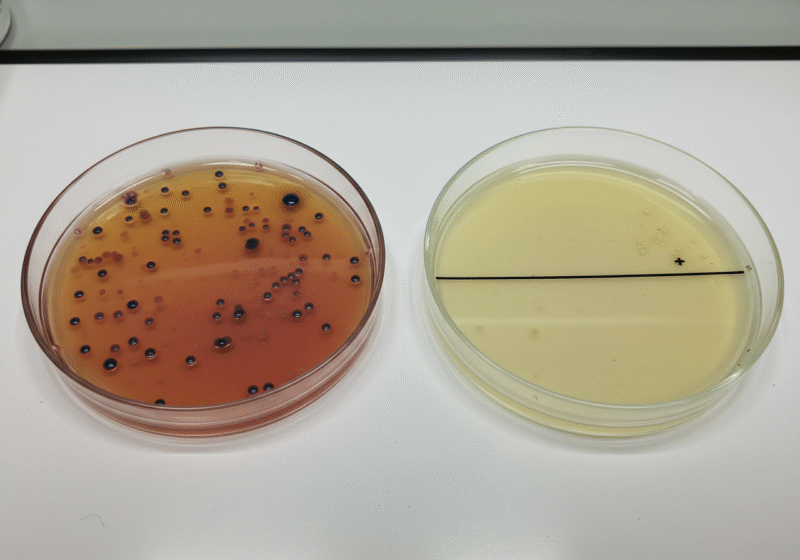

空気清浄機業界にディスラプションを起こした「プラズマラボ」の挑戦
― フィルターでは届かない領域に、Wプラズマが切り込む ―
長年、空気清浄機の主流は「フィルターによる空気の濾過」でした。花粉やホコリ、PM2.5など、目に見える・あるいは微細な粒子を捕集するというアプローチは一定の効果を持ち、家庭用として広く普及してきました。しかし、ウイルスという見えない脅威には、この従来型の空気清浄機では不十分であるという事実に、多くの人は気づいていません。

ウイルスの多くは400〜700nm(ナノメートル)よりも小さく、光学顕微鏡では可視化できないサイズです(※注1)。つまり、通常のフィルターを通過してしまう可能性があり、「捕まえる」ことすら困難な存在なのです。加えて、たとえ捕集できたとしても、ウイルス自体の「不活化」や「除菌」まではできないのが、従来型の限界でした。そんな中、空気清浄機業界にディスラプション(破壊的イノベーション)をもたらしたのが『プラズマラボ』です。
ウイルスは空気清浄機のフィルターを素通りしてしまう
■ Wプラズマ技術で、空間そのものを除菌
プラズマラボが開発した空間除菌機は、「Wプラズマ技術」を核に据えています。
この技術は、オゾンガスと高密度マイナスイオンを同時に発生させることで、空気中に浮遊するウイルスや細菌を直接・積極的に不活化・除菌することを可能にしています。

オゾンは強い酸化力を持ち、ウイルスの殻(エンベロープ)を破壊し、不活化する力を持つことが知られています。一方、マイナスイオンはウイルスや菌の表面に付着し、変性を促進します。この二段構えのアプローチ=Wプラズマ技術が、従来型の「受け身のフィルタリング」ではなく、「空間そのものをクリーン化する」というアクティブな空気清浄の概念を確立したのです。
■ フィルターの限界を超えた、新しい選択肢
もはや「空気清浄機」という枠組みを超え、「空間除菌機」としての地位を確立しつつあるプラズマラボの製品。
感染症対策が求められる現代において、ウイルスを“除去する”のではなく“無力化する”という視点が、今後の空気浄化技術のスタンダードとなるかもしれません。
空気清浄という当たり前の技術に革新をもたらしたプラズマラボ。
その挑戦は、私たちの“安心して深呼吸できる空間”を再定義しています。
※注1:ウイルスのサイズは種により異なるが、インフルエンザウイルスは80〜120nm、新型コロナウイルスは約100nm前後とされている。
■ 株式会社 食環境衛生研究所(食環研)による科学的エビデンス
プラズマラボの除菌機能は、第三者機関である株式会社 食環境衛生研究所(通称 食環研)によって厳しく検証されています。
この機関はISO/IEC 17025国際認定の試験所であり、食品・環境の衛生検査を専門に行う業界有数の信頼機関です
- 大腸菌:99.9%除菌(30分運転)
- 黄色ブドウ球菌:99.8%除菌(30分運転)
- インフルエンザウイルスA型:99.6%不活化(60分運転)
- ノロウイルス代替ウイルス(ネコカリシウイルス):99.9%不活化(60分運転)
これらはすべて食環研による実験結果で、明確な数値が公式に認定・掲載されています。
■ フィルターの限界を超えた、新しい選択肢
プラズマラボの技術は、もはや従来の「空気清浄機」ではなく、「空間除菌機」としての地位を築きつつあります。
感染症対策が求められる現代、「ウイルスを“除去”する」のではなく「“不活化”する」という視点が、次世代の空気浄化技術のスタンダードになる可能性があります。
空気清浄という常識に、科学的データと革新的技術で挑んだプラズマラボ。
その挑戦は、私たちの“安心して深呼吸できる空間”を再定義します。


コメント
コメント ( 0 )
トラックバックは利用できません。
この記事へのコメントはありません。